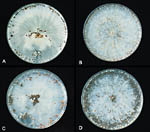

Southern blight, Southern stem blight, White mold
Sclerotium rolfsii (teleomorph: Athelia rolfsii)
More than 500 plant species including apple, peanut, potato, tomato; also many woody ornamentals, herbaceous annuals and perennials including aucuba, forsythia, azalea, hydrangea, viburnum, ageratum, begonia, columbine, coneflower, marigold, pansy, petunia, and zinnia.
Southern blight, caused by the soilborne fungus Sclerotium rolfsii is a serious disease of a wide variety of plants, including field, vegetable, fruit, ornamental crops and also turf. S. rolfsii usually infects the lower stem near the soil surface. With some plants, the roots may become infected. The disease occurs worldwide, but predominantly in warm climates. In 1928, the USDA reported that S. rolfsii and root knot nematode caused more damage in the southern USA than any other pathogen. In recent years, southern blight has been especially damaging on cotton in Arizona, peanut and tomato in the Southeast, and sugar beet in California. Despite considerable research on this disease, control of southern blight continues to be a problem.
A viburnum trunk base infected by Sclerotium rolfsii. |
Symptoms and signs
Sclerotium rolfsii infects seedlings, herbaceous plants, woody plants, and fleshy roots, bulbs or fruits. Most frequently, this fungus infects lower stems near or at the soil surface, but it also may infect any part of a susceptible plant as long as favorable environmental conditions exist. The first symptom usually noticed by the homeowner or grower is wilt. Wilted plants often decline and die rapidly as a result of an extensive lower stem rot.
Crown and Lower Stem Rot
On tomato, peanut, pepper, and many other herbaceous and woody hosts, disease begins with a small, water-soaked lesion on the lower stem at or near the soil surface (Figure 1). The lesion spreads rapidly to girdle the stem (Figure 2). On many herbaceous plants and seedlings, the girdling lesion will quickly cause the plant to wilt (Figure 3) and fall over. With container Hosta, older and lower foliage wilts, becomes yellow and then brown. Lower stems (crowns) often become rotted, but rotting may not extend completely throughout the crown tissues. Hosta plants may or may not completely die as a result of infection. On mature pepper and tomato, the stem cortex several centimeters (inches) above and below the soil surface will decay, but the stem central cylinder does not decay. As the lower stem decay develops, plants usually remain erect and foliage wilts. On many host plants, wilted leaves gradually become brown and remain hanging on the plant (Figure 4).
 Figure 1 |
 Figure 2 |
 Figure 3 |
 Figure 4 |
On peanut, one or more branches may wilt and leaves on these branches appear slightly faded and then turn brown (Figure 5) . A few branches often survive on each plant. Peanuts infected in dry weather will have 2.0 - 2.5 cm (~1 in.) cankers located 2 - 3 cm (1-2 in.) below the soil line. Only one canker is usually seen per plant. When stems are partly girdled, leaves are often small with a mild brown coloration, but wilt does not occur. When peanuts are infected in wet, hot weather, stems become totally rotted except for the xylem.
 Figure 5 |
As lower stems of herbaceous plants decay, a white mat of mycelium develops at the lesion site (Figure 6). This white mat will often spread out onto the nearby soil surface. Shortly after the mycelial mat develops, small (0.5-1 mm), white, round, fuzzy mycelial bodies begin to appear (Figure 7). These mustard-seed-sized structures, called sclerotia, soon become smooth and light tan, brown or black in color (Figures 8,9). Sclerotia serve as overwintering bodies and may be seen in the mycelium, on diseased tissues above or below ground, on soil surfaces, or in soil crevices.
 Figure 6 |
 Figure 7 |
 Figure 8 |
 Figure 9 |
Sclerotium rolfsii infections of woody plants usually begin as a crown rot. Characteristic white mycelial mats and sclerotia also develop at the crown infection sites when conditions are favorable (Figures 10, 11). Foliage wilting and dieback develop as a consequence of the rotting of the lower trunk or crown tissues (Figure 12).
 Figure 10 |
 Figure 11 |
 Figure 12 |
When monocots such as wheat and some other grasses are infected, symptoms and signs of the disease are different from those described above for dicots. Brown lesions occur at the crown and lower parts of the culm. Lesions are often small, but they may extend into the hollow part of the culm. Strands of mycelium grow inside the lower internodes. Seedheads may appear normal, but they are devoid of grain. Premature ripening also may occur. On millet, grain sorghum, and tall fescue, the leaf sheath becomes water-soaked, and the brown discoloration turns to dark brown or black. Mats of white mycelium develop and spread upward inside and outside the leaf sheaths (Figure 13). The mycelium eventually spreads over the base of grass blades where sclerotia develop (Figure 14). Southern blight is not common on wheat and small grains, but it does occur on cool season turf species such as bentgrass, fescue, perennial ryegrass, bluegrass, and broad leaf turf species such as Dichondra spp. when conditions are warm (above 24ºC / 75ºF) and moisture is abundant.
 Figure 13 |
 Figure 14 |
Root Decay
On some plants, such as tomato, pepper, and sweet potato, root infection may follow crown infection. On apples, roots are the primary infection site and crown rot develops subsequently. Usually the characteristic white mycelial mat and sclerotia develop near and on infected crown tissues or in and around roots close to the soil surface (Figures 10, 11, 15 ). The leaves eventually die, and branch dieback develops (Figure 4). The lower stem (trunk) above the girdling lesion usually appears normal for a long time and will be the last part of the plant to die.
 Figure 15 |
 Figure 16 |
Tuber, Bulb, and Fleshy Organ Rot
Sclerotium rolfsii causes a soft rot of fleshy organs. On potato tubers, small slightly sunken lesions (2-3 mm) at lenticels will develop into yellow-tan colored lesions. Tissues become soft and collapsed. Mycelium and sclerotia develop abundantly on rotting tissues (Figure 16). Sometimes bacteria enter the previously damaged tissues, and a sour odor is noted. When narcissus bulbs become infected, several layers of scales become reddish brown with white streaks. Rotted tissues are initially moist, but later tissues dry and smell of dried, rotted wood. Sclerotia develop in the rotted areas.
Fruit
Tomato fruit and other fruit at or near the soil surface may become infected with S. rolfsii. Soft, water-soaked, sunken, slightly yellowish lesions develop. These lesions quickly spread throughout most or all of the fruit, which will eventually collapse. Coarse white mycelium develops with sclerotia (Figure 17).
 Figure 17 |
 Figure 18 |
Leaves
On low growing plants such as strawberries, statice, and peanut, leaves touching the soil may be infected with S. rolfsii. Necrotic leaf spots have been described on many plants (Figure 18). Usually the high humidity near the soil surface is an important factor in disease development. There have been some reports of leaf spots at locations considerably above the soil. For example, S. rolfsii has been reported to cause a leaf spot on tung oil trees on leaves 2-3 m (6-9 ft) above ground level. Also, an unusual leaf spot has been described on soybean in North Carolina. The spots are circular, medium brown to light brown or straw-colored with narrow borders and are usually one cm or less in diameter. Many of the lesions have concentric rings, and small clumps of mycelium on them often develop into sclerotia.
Pathogen Biology
Sclerotium rolfsii (teleomorph Athelia rolfsii)
Asexual Stage (anamorph)
Sclerotium rolfsii produces an abundant white, coarse mycelium on infected host tissues usually 3-4 days after infection when conditions are warm and humid (Figure 19). The main branch hyphae are relatively large (5-9 microns in diameter) compared to many other fungi that more typically have hyphal diameters of 2-4 microns. These main branch hyphae are described as hyaline (colorless) and thin-walled with infrequent cross walls and clamp connections (Figure 20). Smaller diameter (2-4 microns) hyphal cells, called ‘feeding branches’, arise from and penetrate the plant tissue. When observed with the naked eye, the mass of hyphae appears white, and the thick, large hyphal cells will be abundant enough on infected tissues to form a white fungal mat on lower stems and at the soil surface.
 Figure 19 |
 Figure 20 |
About seven days after infection, the hyphae begin to form sclerotia. Spherical, fuzzy bodies begin to form from closely packed areas of hyphae or where two hyphal strands cross each other. Gradually the bodies become smooth and change in color from white to light tan to brown and possibly to black (Figure 15 ). Mature sclerotia typically consist of an outer thickened and tough rind (2-4 cells thick) which surrounds a cortex of thin-walled cells (6-8 cells thick). The center of the sclerotium contains loosely arranged filamentous hyphae. Sclerotia are typically 0.5 - 2 mm diameter, but some can become as large as 8 - 10 mm diameter. Segments of hyphae can serve as inoculum, and the fungus can overwinter as mycelium in infected plants, plant debris, or as sclerotia. Sclerotia may remain viable for several years in soil, potting media, or on plant debris in areas with mild winters. Studies have shown that S. rolfsii sclerotia survived when buried just below the surface, at 15 cm and at 30 cm depths for one winter in two locations in Iowa. S. rolfsii does not produce any asexual spores.
Sexual Stage (teleomorph)
In 1926, the sexual stage of this basidiomycetous fungus was first described in Japan. The currently accepted name for the teleomorph is Athelia rolfsii. The sexual stage is not commonly seen. As in other Basidiomycetes, A. rolfsii produces a structure called a basidium in which meiosis occurs. Four haploid basidiospores are produced at the tips of small structures on the basidium called sterigmata (Figure 21). Athelia rolfsii produces basidia in an unprotected layer (hymenium), which develops under humid conditions at the margins of lesions. The hymenium appears as a white, yellow, or buff-colored granular or encrusted area with a slightly wavy surface. The basidia are obovoid (oval shaped with one end being narrower than the other), 7-9 microns long and 4-5 microns wide. When mature, the basidiospores are forcibly discharged.
 Figure 21 |
Disease Cycle and Epidemiology
In the spring, hyphal growth resumes from infected tissues and germinating sclerotia (Figure 22). When hyphae come into contact with susceptible crown, root, bulb, fruit or leaf tissues, direct penetration occurs, but wounds facilitate infection (Figure 18).
 Figure 22 |
 Figure 18 |
Infection of lower stems, roots, bulbs, fruits, and leaves may occur if tissue is susceptible and if temperature, humidity and other environmental factors are favorable. Hyphae may be intracellular or intercellular. The fungus produces oxalic acid, polygalacturonase and cellulase, all of which act to cause separation and death of cells. Within 2-4 days after infection, symptoms of soft rot are usually apparent (Figures 1, 2). When the lower trunk or stem is girdled by the soft rot canker, foliage wilt, branch dieback, and complete plant death often result (Figure 4).
 Figure 1 |
 Figure 2 |
 Figure 4 |
Secondary cycles occur and disease spreads as hyphae contact new healthy susceptible tissues when warm to hot temperatures and humid conditions prevail during the growing season. Also, basidiospore production may contribute to secondary cycles (Figure 21). Once basidiospores make contact with the plant surface, spores swell and produce 1-3 germination tubes. Each germ tube may produce appressoria (swollen cushion-like structures) from which a penetration peg is produced.
 Figure 21 |
The fungus overwinters as sclerotia and mycelium in infected plants and plant debris and sometimes as developing hymenial layers. Most sclerotia are produced at or near the soil surface and survive longer in well-drained soil (Figures 8, 9, 10, 14).
 Figure 8 |
 Figure 9 |
 Figure 10 |
 Figure 14 |
Epidemiology
Southern blight is a problem in warm and wet tropical and subtropical areas. The pathogen survives as mycelium on dead organic material when living susceptible plants are not present. It also survives as sclerotia in soil. Research has shown that fungal infection is enhanced when dead organic materials are available around susceptible plants.
Temperature and moisture are very important factors in the spread and development of this pathogen. Hyphal growth occurs over a temperature range of 8-40ºC / 46-104º F, but optimal growth and sclerotia production occurs between 27-35ºC / 81-95ºF. In addition to temperature effects, hyphal growth and sclerotia germination require a water-saturated soil. High humidity also favors fungal development. At 27ºC / 81ºF on potato dextrose agar, the hyphal growth rate of S. rolfsii has been observed to be 0.8-0.9 mm per hour. Sclerotia form after 5-7 days (Figure 23). Host penetration and infection will proceed optimally at 27-30ºC / 81-86ºF, provided that moisture and high humidity are present.
Figure 23 |
Current season spread of S. rolfsii within a planting occurs by mycelial growth from infected plants, plant debris, or sclerotia. Long distance spread occurs as a result of movement of infected plant material or infested soil. Studies have shown that sclerotia may pass through the digestive tract of cattle or sheep and still be viable.
S. rolfsii survives adverse conditions as sclerotia or as mycelium in diseased plants or plant debris. Sclerotia formation is favored by temperature of 30ºC / 86ºF, ample moisture, soil pH below 7, and well-aerated, light soil. Sclerotia survive best when present at or near the soil surface in well-drained soil. Research has demonstrated that no sclerotia survived when buried 15 cm (6 in.) deep for 45 days. Mycelium does not usually survive below freezing temperatures, but sclerotia are known to survive in locations where below freezing temperatures have occurred.
S. rolfsii has been reported as unusual occurrences in New York, Washington, Oregon, Indiana, Illinois, and Siberia. The fact that this fungus is usually a problem in warm climate regions indicates that sclerotia must not be tolerant of severely cold temperatures.
Management of Southern Blight
Sclerotium rolfsii is a soilborne pathogen with a very wide host range of over 500 plant species. As with most fungal soilborne plant pathogens, disease management involves exclusionary practices, plant removal, soil removal or treatment, plant treatment, crop rotation, use of resistant varieties, or a combination of these practices. The specific management practices used depend upon the crop and cropping situation.
Excluding the Pathogen from an Area
Only pathogen-free plants, cuttings or seeds should be purchased from a reputable dealer. In a greenhouse, all pots and planting equipment must be clean and pathogen-free, and planting media also must be pathogen-free. If field planting is involved, areas that do not have a history of S. rolfsii should be selected. Even though southern blight is not common in areas with cold winters, the disease may be a problem during the growing season if infected transplants from greenhouses or warmer regions are planted.
Plant Removal
As with many plant diseases, removal of infected plants is an important aspect of disease control. Sclerotium rolfsii usually causes infection at the lower stem (crown) section of the plant, and once infection takes place, removal of the whole plant is necessary. Prompt removal of infected plants will help prevent the addition of abundant fungal inoculum to the soil. If infected plants are allowed to remain in an area, these plants will serve as a continuous source of inoculum. Plant removal is a practical measure in landscapes, gardens, nurseries, and greenhouses, but not in field situations.
Soil Removal
Sclerotia are reported to survive in the soil for 3-4 years. In gardens or landscapes, some localized soil removal and replacement may help to control S. rolfsii. The grower should take care not to increase the distribution of the fungal inoculum in an area when transporting soil. In nurseries and greenhouses, used potting media should not be saved for new plants. Plant debris and used media should be thoroughly cleaned out of production areas after each crop is removed. Recycled containers should be thoroughly cleaned so as to remove all old pot media.
Soil Treatment
Treating the soil with heat (including solarization), fungicides or fumigants, cultural manipulations, organic amendments, fertilizers, or biological treatments may help to control southern blight.
Heat. In some large nurseries or greenhouses, it may be possible to treat beds or bulk soil with aerated steam. All areas must be brought to a temperature of 160-180 degrees F for 30 minutes. Treated soil should be stored away from contaminated areas. Even after steam treatment, some sclerotia may survive and losses may occur.
Solarization. Solarization for southern blight control has been beneficial in select situations in the southern United States. Successful solarization requires that the soil is prepared properly as for planting. Adequate soil moisture must be present. Clear plastic sheeting, 0.025 - 0.4 mm thick, must be applied to the area for 4-8 weeks, depending upon the time of year (Figure 24). For example, plastic applied during the month of June in Alabama would require a shorter exposure time of 4 weeks due to the high temperatures. Treated areas should receive direct and full sunlight. Soil solarization will significantly reduce viable sclerotia. It will also help control other soilborne diseases, plant parasitic nematodes, and some weeds. To be effective in control of southern blight, solarization must be repeated every year. Soil solarization is expensive, and it is not practical for use in large field situations.
 Figure 24 |
Chemical soil treatments. Soil fungicides or fumigants have been successfully used to control S. rolfsii. The soil fungicide pentachloronitrobenzene (PCNB) has been used on peanuts and some other crops since the 1940s. In a recent peanut trial, azoxystrobin applied as preplant and postplant furrow treatments significantly controlled southern blight. However, applying fungicides to soil may require large quantities of chemical which is not practical in many situations. Also, fungicide effectiveness is not always consistent from year to year. With some ornamentals in commercial production situations, the fungicides azoxystrobin, flutolanil, flutolanil + thiophanate-methyl, and/or tebuconazole are labeled for pre- and post plant drenches. Fumigants, such as metam sodium or dazomet (granular), are toxic to sclerotia and mycelium in the soil. But, even after treatment with fumigation, some sclerotia survive, and treatments must be repeated annually. These fumigant chemicals are restricted-use products and may only be applied by certified applicators (Figures 25, 26).The toxicity and cost of fumigants limit their usefulness in many situations. Methyl bromide was used for many years to help control southern blight but it is no longer available, due to its detrimental effects on the ozone layer of the atmosphere. In addition to the more conventional soil treatments of fungicides or fumigants, a soil insecticide (chlorpyrifos) is also labeled for use as a soil treatment to control S. rolfsii in certain peanut cropping situations.
 Figure 25 |
 Figure 26 |
Cultural practices. Cultural modifications for management of S. rolfsii in the landscape include deep plowing, lime additions, aerification, and thatch removal. In some situations, deep plowing will provide disease control. At depths below 20-30 cm [8-12 in.]), sclerotia do not survive longer than 45 days. Also, deep plowing removes sclerotia from contact with root tissues. Although deep plowing is effective the first time, it may not work in subsequent years because sclerotia are returned to the upper soil layer. Keeping the soil pH at 6.5 by the addition of lime will help to prevent rapid fungal growth. Aerification of the soil and removal of thatch or other plant debris will also aid in suppressing S. rolfsii growth. In greenhouses, areas should be kept open with good plant spacing to help keep relative humidity low. Also, keeping the temperature below 25ºC / 77ºF and maintaining well-aerified plant media will discourage fungal growth. Nurseries must be designed to carry drainage water away from container areas.
Soil amendments, fertilization, biological agents and plant-produced chemicals. Soil can be treated with organic amendments, fertilizers, or biological agents to help control S rolfsii. The addition of organic amendments such as compost, oat or corn straw, or cotton gin trash to soil sometimes reduces southern blight incidence and development. This effect may be due to the increase of toxic ammonia and/or the increase of certain soil microorganisms in the soil. Furfuraldeyde, an organic (sugar derivative) amendment, has been shown to change the soil microflora, and this change has been related to a decrease of S. rolfsii in the soil in lab and greenhouse studies. Also, neem oil and pine bark extracts or pine bark powder have resulted in reduced growth of S. rolfsii. To date, these amendments have not been widely used for disease control, but future refinements may allow their use in the field. Fertilizer studies have shown that treatments with ammonium, calcium nitrate or calcium sulfate may help control southern blight. Increased nitrogen may inhibit sclerotia germination, alter host susceptibility, or alter the soil microorganisms. Biological control of S. rolfsii has been achieved to some degree with bacteria (Bacillus subtilis), actinomycetes, a mycorrhizal fungus, or certain Trichoderma species. There have been several studies to attempt to explain the mechanism for Trichoderma inhibition of S. rolfsii. Many studies have shown disease control by biological agents in laboratory and greenhouse tests, but disease control is less effective in the field. When control is seen in field studies, the required quantity of the biological product may be very high and not practical in most agronomic situations. In addition to the above, certain compounds in some aster roots and mustards are being studied for their inhibitory activity against this pathogen. At the present time, soil amendments, fertilization products, biological agents and plant-produced chemicals have not been widely adopted for southern blight control.
Crop Rotation
When soilborne plant pathogens are involved, crop rotation is a common and preferred method of disease control. This practice is not used much with southern blight because of the unusually wide host range of S. rolfsii. Corn is reported to be a non-host of this pathogen. When infested fields are rotated to corn, inoculum levels in the soil slowly decrease, and lower disease incidence will be seen in subsequent years. Some field research has shown that peanut rotations with cotton, ‘Pensacola’ bahia grass (Paspalum notatum), or switch grass (Panicum virgatum) resulted in a decreased incidence of white mold (stem rot) in peanut fields.
Plant Treatments
Plant treatments with fungicides for control of southern blight are generally protective in nature. Most fungicides are labeled for use on select ornamentals, vegetables, or some field crops. On peanuts, good disease control has been achieved by foliar applications of azoxystrobin products, flutolanil, or tebuconazole. PCNB is a fungicide that was used for many years to control S. rolfsii on some ornamentals, peanuts, some vegetables, and as a seed treatment. The product is available as a granular or liquid formulation. In 1998, PCNB no longer provided control of S. rolfsii in some Texas peanut fields. Fungal isolates tolerant to PCNB had developed. Southern blight control in peanut usually involves protective treatments with fungicides. However, good disease control has also been achieved with the insecticide chlorpyrifos, which is hydrolyzed into a fungicidal product, or with the nematicide ethoprop (mode of action unknown). For many years the only fungicide labeled to control southern blight on aucuba and several other ornamentals was PCNB. We now have the fungicides azoxystrobin, flutolanil, flutolanil + thiophanate-methyl, and tebuconazole in addition to PCNB available for use on select ornamentals for control of southern blight. Many of these products are labeled for pre- and post plant drench or broadcast application.
Resistance and Transgenic Plant Resistance
The use of resistant varieties or cultivars is always a much preferred method of disease management or control. Unfortunately, many common host plant species of S. rolfsii do not contain cultivars or varieties that exhibit high levels of resistance to this fungus. Nevertheless, research in this area continues. Some recent cultivar studies were done on Hosta, peanut, and cowpea. In 2003, 18 Hosta cultivars in a greenhouse study were evaluated for their resistance to S. rolfsii infection and disease development. Variable symptom severity resulted, but complete resistance to S. rolfsii was not reported. Recent inoculation studies with peanuts and cowpeas showed there were differences in disease susceptibility between some cultivars. And, preliminary results from a recent laboratory study with transgenic carrots indicated a reduced susceptibility to S. rolfsii.
Significance
Historical Significance
In 1892, Peter Henry Rolfs first published a description of a new disease on tomato where some fields in Florida showed a greater than 70% loss. The fungus was named Sclerotium rolfsii by Saccardo in 1911. Descriptions of the disease in Connecticut, Louisiana, North Carolina, Japan, Ceylon, and India were published in the early 1900s. In 1928, the USDA reported that S. rolfsii and root-knot nematode caused more damage in southern states than any other pathogens. In the first half of the 20th century, peanut production sustained losses of 10-20 million dollars annually due to this disease. Losses of 25-50% were not uncommon in 1938-1947. By 1944, the disease was known to occur in 24 states (Figure 27). By 1966, there were almost 2000 publications on this disease in various locations around the world, but mostly from tropical and subtropical areas.
 Figure 27 |
Current Significance
Sclerotium rolfsii continues to be a problem in a variety of crops when conditions are warm, humid and rainy. Today this disease occurs around the world in the equatorial zone between the 45º N and S latitudes. It is commonly found in the United States, Central America, the Carribbean area, South America, countries bordering the Mediterranean Sea, Africa, India, Japan, the Philippines, Hawaii, Australia, and New Zealand. Occasionally, southern blight has been reported in North China, Europe, and some northern areas of the United States, including Indiana, Illinois, and New York. There has been one report from Siberia. In the southern United States, S. rolfsii has been especially damaging on cotton in Arizona, on peanut and tomato in many areas of the Southeast, and on sugar beet in California. During the middle of the 20th century, this disease was controlled to some degree by fumigation or soil applied fungicides. These chemicals are often too expensive and too toxic for many situations, and future uses of fumigants are being restricted due to environmental concerns. Today, control of this fungus disease is still the subject of many research projects involving chemicals, biological agents, soil amendments, cultural modifications, disease physiology, nutrition studies, and cultivar/variety resistance. Despite these efforts, S. rolfsii, like many other soilborne fungal disease agents, continues to be a difficult pathogen to control.
Selected References
Aycock, R. 1966. Stem rot and other diseases caused by Sclerotium rolfsii. North Carolina Agricultural Experiment Station Technical Bulletin. 174. 202 pp.
Bowen, K.L., A.K. Hagan, and J.R. Weeks. 1992. Seven years of Sclerotium rolfsii in peanut fields: Yield losses and means of minimization. Plant Disease. 76:982-985.
Bulluck, L.R. III, and J.B. Ristaino. 2002. Effect of synthetic and organic soil fertility amendments on southern blight, soil microbial communities, and yield of processing tomatoes. Phytopathology 92(2): 181-189.
Canullo. G.H., R. Rodriguez-Kabana, and J.W. Kloepper. 1992. Changes in soil microflora associated with control of Sclerotium rolfsii by furfuraldehyde. Biocontrol Science and Technology 2:159-169.
Cattalan, A.J., P.G. Hartel, and J.J. Fuhrmann, 1999. Screening for plant growth-promoting rhizobacteria to promote early soybean growth. Soil Science Society of America Journal 63(6): 1670-1680.
Chellemi, D.O., S.M. Olson, D.J. Mitchell, J. Sicker, and R. McSorley. 1997. Adaptation of soil solarization to the integrated management of soilborne pests of tomato under humid conditions. Phytopathology 87:250-252.
Edmunds, B.A. and M.L. Gleason. 2003. Perennation of Sclerotium rolfsii var. delphinii in Iowa. Plant Health Progress (http://www.plantmanagementnetwork.org/pub/php/research/2003/overwinter/)
Edmunds, B.A., M.L. Gleason, and S.N. Wegulo. 2003. Resistance of Hosta cultivars to petiole rot caused by Sclerotium rolfsii var. delphinii. HortTechology 13(2): 302-305.
Fery, R. L. and P.D. Dukes Sr. 2002. Southern blight (Sclerotium rolfsii Sacc.) of cowpea: yield-loss estimates and sources of resistance. Crop Protection 21(5): 403-408.
Grecher, W.J. 1995. Management of stem rot of peanuts (Arachis hypogaea) caused by Sclerotium rolfsii with fungicides. Crop Protection 14:111-115.
Hagan, A. 2006. Alabama Pest Management Handbook, Volume A and B. Ed. J. Everest. Alabama Cooperative Extension System. ANR-500A and B. (http://www.aces.edu/pubs/docs/A/ANR-0500-A/; http://www.aces.edu/pubs/docs/A/ANR-0500-B/)
Hagan, A.K., H.L. Campbell, J.R. Weeks, and M. Pegues. 2006. Performance comparison of peanut cultivars for 2003-2005 at the Gulf Coast Research and Extension Center. Alabama Cooperative Extension System. PP-604. Timely Information. 4p. (http://www.aces.edu/timelyinfo/)
Hagan, A. 2004. Southern blight on flowers, shrubs, and trees. Alabama Cooperative Extension System Publication, ANR-1157. (http://www.aces.edu/pubs/docs/A/ANR-1157/).
Hagan, A.K. and J.W. Olive. 1999. Assessment of new fungicides for the control of southern blight on aucuba. Journal of Environmental Horticulture 17:73-75.
Kokalis-Burelle, N. and R. Rodriquez-Kabana. 1994. Effects of pine bark extracts and pine bark powder on fungal pathogens, soil enzymatic activity, and microbial populations. Biological Control 4: 269-276.
Kokalis-Burelle, N., W.F. Mahaffee, R. Rodriquez-Kabana, J.W.Kloepper, and K.L. Bowen. 2002. Effects of switchgrass (Panicum virgatum) rotations with peanut (Arachis hypogaea L.) on nematode populations and soil microflora. Journal of Nematology 34(2): 98-105.
Mehan, V.K., C.D. Mayee, and D. McDonald.1994. Management of Sclerotium rolfsii-caused stem and pod rots of groundnut - a critical review. International Journal of Pest Management 40:313-320.
Pattmark, S., V.R. Subramanyam, and C. Kole.1996. Antibacterial and antifungal activity of ten essential oils in vitro. Microbios 86: 237-246.
Punja, Z.K. 1985. The biology, ecology, and control of Sclerotium rolfsii. Annual Review of Phytopathology 23:97-127.
Punja, Z.K. 2005. Transgenic carrots expressing a thaumatin-like protein display enhanced resistance to several fungal pathogens. Canadian Journal of Plant Pathology 27(2): 291-296.
Rodriguez-Kabana, R., N. Kokalis-Burelle, D.G. Robertson, P.S. King, and L.W. Wells. 1994. Rotations with coastal bermuda grass, cotton, and bahiagrass for management of Meloidogyne arenaria and southern blight in peanut. Journal of Nematology 26:4 Supp, 665-668.
Shem, M.Y., J.L. Starr, N.P. Keller, K.E. Woodard, and T.A. Lee, Jr. 1998. Distribution of isolates of Sclerotium rolfsii tolerant to pentachloronitrobenzene in Texas peanut fields. Plant Disease 82:103-106.
Singh, R.K. and R.S. Dwivedi.1991. Ecology and biology of Sclerotium rolfsii Sacc. International Journal of Tropical Plant Diseases 9:161-171.
Taylor, C. R. and R. Rodriguez-Kabana. 1999. Optimal rotation of peanuts and cotton to manage soil-borne organisms. Agricultural Systems 61(1): 57-68.
Tsahouridou, P.C. and C.C. Thanassoulopoulos. 2002. Proliferation of Trichoderma koningii in the tomato rhizosphere and the suppression of damping off by Sclerotium rolfsii. Soil Biology and Biochemistry 34 (6): 767-776.